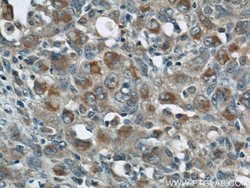
ZAP70 Rabbit anti-Human, Mouse, Polyclonal, Proteintech 20 &mu;L; Unconjugated:Antibodies,

missing translation for 'onlineSavingsMsg'
Learn More
Learn More
ZAP70 Rabbit anti-Human, Mouse, Polyclonal, Proteintech
Rabbit Polyclonal Antibody
Brand: Proteintech 22207-1-AP-20UL
This item is not returnable.
View return policy
Description
Interacts with phosphorylated C-terminal heptapeptide repeat domain (CTD) of the largest RNA polymerase II subunit POLR2A, and participates in dephosphorylation of the CTD. Transcriptional regulator which enhances expression of CCND1. Promotes binding of RNA polymerase II to the CCDN1 promoter and to the termination region before the poly-A site but decreases its binding after the poly-A site. Prevents RNA polymerase II from reading through the 3′ end termination site and may allow it to be recruited back to the promoter through promotion of the formation of a chromatin loop. Also enhances the transcription of a number of other cell cycle-related genes including CDK2, CDK4, CDK6 and cyclin-E but not CDKN1A, CDKN1B or cyclin-A. Promotes cell proliferation.Specifications
| ZAP70 | |
| Polyclonal | |
| Unconjugated | |
| ZAP70 | |
| 70 kDa zeta associated protein, SRK, STD, Syk related tyrosine kinase, Tyrosine protein kinase ZAP 70, TZK, ZAP 70, ZAP70 | |
| Rabbit | |
| Antigen Affinity Chromatography | |
| RUO | |
| 22637, 7535 | |
| -20°C | |
| Liquid |
| Immunohistochemistry (Paraffin), Western Blot, Immunocytochemistry, Immunoprecipitation, Immunofluorescence | |
| 0.39 mg/mL | |
| PBS with 50% glycerol and 0.02% sodium azide; pH 7.3 | |
| P43403, P43404 | |
| ZAP70 | |
| ZAP70 Fusion Protein Ag17527 | |
| 20 μL | |
| Primary | |
| Human, Mouse | |
| Antibody | |
| IgG |
Product Content Correction
Your input is important to us. Please complete this form to provide feedback related to the content on this product.
Product Title
Spot an opportunity for improvement?Share a Content Correction